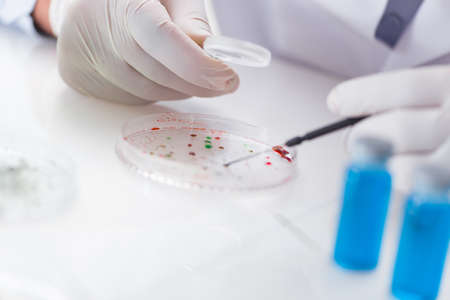
Male doctor working in the lab on virus vaccineの写真素材

写真素材 - Male doctor working in the lab on virus vaccine
キーワード
- analyzing
- biochemistry
- biology
- biotechnology
- blood
- chemical
- chemist
- chemistry
- clinic
- clinical
- closeup
- dna
- doctor
- equipment
- exam
- examining
- experiment
- flask
- glass
- health
- healthcare
- lab
- laboratory
- looking
- loupe
- magnifier
- magnifying
- male
- man
- medical
- medicine
- microbes
- microbiology
- microscope
- pharmaceutical
- pharmacology
- pharmacy
- research
- researcher
- sample
- science
- scientific
- scientist
- student
- studying
- syringe
- test
- tube
- vaccine
- virus
類似作品